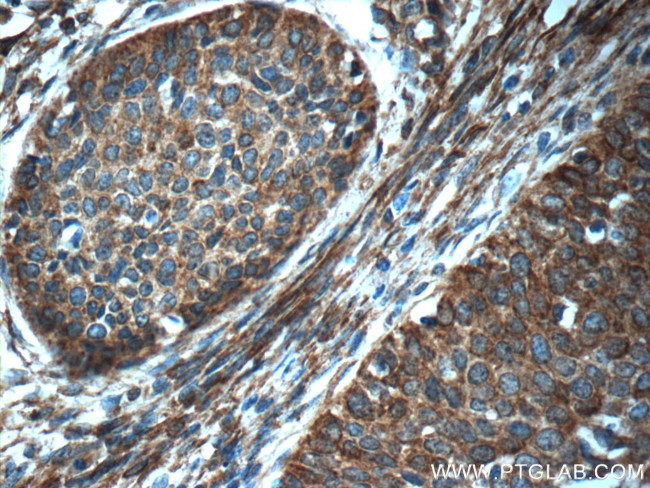
SFRP4 Antibody in Immunohistochemistry (Paraffin) (IHC (P))
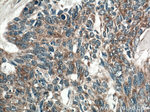
SFRP4 Antibody in Immunohistochemistry (Paraffin) (IHC (P))

Search
Proteintech
SFRP4 Polyclonal Antibody
{{$productOrderCtrl.translations['antibody.pdp.commerceCard.promotion.promotions']}}
{{$productOrderCtrl.translations['antibody.pdp.commerceCard.promotion.viewpromo']}}
{{$productOrderCtrl.translations['antibody.pdp.commerceCard.promotion.promocode']}}: {{promo.promoCode}} {{promo.promoTitle}} {{promo.promoDescription}}. {{$productOrderCtrl.translations['antibody.pdp.commerceCard.promotion.learnmore']}}
产品信息
15328-1-AP
种属反应
已发表种属
宿主/亚型
分类
类型
抗原
偶联物
形式
浓度
规格
纯化类型
保存液
内含物
保存条件
运输条件
产品详细信息
This antibody got 41-51 kDa and 55 kDa bands in western blotting maybe due to differential posttranslational protein modification.
Immunogen sequence: MFLSILVAL CLWLHLALGV RGAPCEAVRI PMCRHMPWNI TRMPNHLHHS TQENAILAIE QYEELVDVNC SAVLRFFLCA MYAPICTLEF LHDPIKPCKS VCQRARDDCE PLMKMYNHSW PESLACDELP VYDRGVCISP EAIVTDLPED VKWIDITPDM MVQERPLDVD CKRLSPDRCK CKKVKPTLAT YLSKNYSYVI HAKIKAVQRS GCNEVTTVVD VKEIFKSSSP IPRTQVPLIT NSSCQCPHIL PHQDVLIMCY EWRSRMMLLE NCLVEKWRDQ LSKRSIQWEE RLQEQRRTVQ DKKKTAGRTS RSNPPKPKGK PPAPKPASPK KNIKTRSAQK RTNPKRV (1-346 aa encoded by BC058911)
靶标信息
Secreted Frizzled-Related Proteins (sFRPs) are a family of glycosylated Wnt antagonists characterized by a conserved cysteine-rich domain that shares homology with the cysteine-rich, extracellular domain Frizzled proteins use for the binding of Wnt proteins and receptors. Lacking the transmembrane and intracellular domains of the Frizzled proteins, sFRPs function as soluble modulators of the Wnt signaling pathway through the direct binding of Wnt proteins to this cysteine-rich domain, and the resultant inhibition of Wnt receptor binding and signaling capabilities. sFRP-4 is widely distributed in a variety of embryonic and adult tissues where it can function as a circulating antiangiogenic factor, a potent proapoptotic factor, an inhibitor of insulin secretion, and a suppressor of both tumor growth and metastatic potential through disruption of the Wnt signaling pathway. Research has demonstrated the existence of a direct correlation between the downregulation and/or absence of circulating sFRP-4 and the progression of several cancer types, including ovarian, endometrial, prostate and lung. Upregulation of circulating sFRP-4 has been linked to the deterioration of glucose metabolism in the case of type 2 diabetes, as well as the suppression of the keratinocyte hyperproliferation and epidermal hyperlasia that are definitive of psoriasis.
仅用于科研。不用于诊断过程。未经明确授权不得转售。
生物信息学
蛋白别名: Frizzled protein, human endometrium; frizzled related protein; FrpHE; MGC26498; Secreted frizzled-related protein 4; secreted frizzled-related protein 4; secreted frizzled-related protein 4; sFRP-4; SFRP4; unnamed protein product
基因别名: FRP-4; FRPHE; FRZB-2; PYL; sFRP-4; SFRP4
UniProt ID: (Human) Q6FHJ7
Entrez Gene ID: (Human) 6424